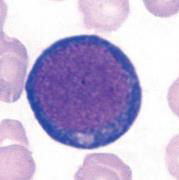
knowt flashcard image
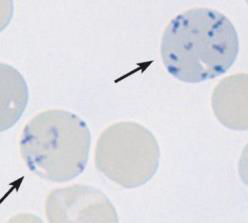
knowt flashcard image
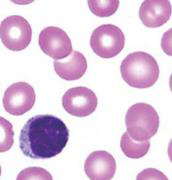
knowt flashcard image
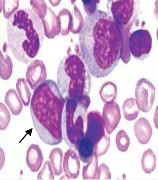
knowt flashcard image
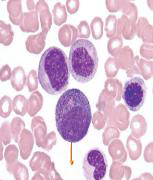
knowt flashcard image
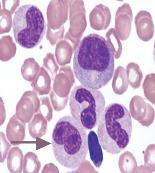
knowt flashcard image
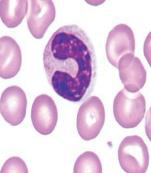
knowt flashcard image
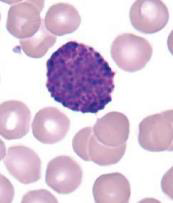
knowt flashcard image
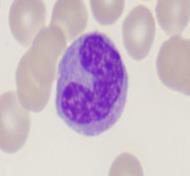
knowt flashcard image
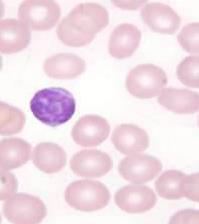
knowt flashcard image
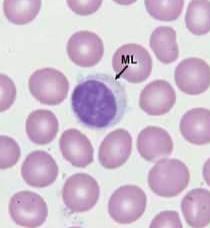
knowt flashcard image
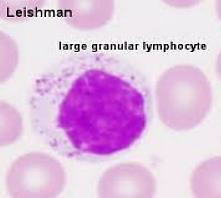
knowt flashcard image
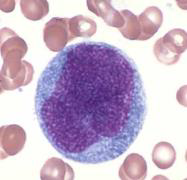
knowt flashcard image
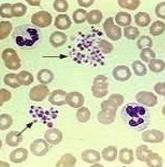
knowt flashcard image

1/38
hema quiz prelims
Name | Mastery | Learn | Test | Matching | Spaced | Call with Kai |
|---|
No analytics yet
Send a link to your students to track their progress
Cytoplasmic Changes
change in cytoplasm
Reduction in Cell Size
more matured, decrease in size
Erythropoiesis
red blood cells
Granulopoiesis
granulocytes/myeloblast
Monopoiesis
monoblast
Lymphoiesis
lymphoblast
Megakaryopoiesis
megakaryocyte
Erythropoiesis
process by which Erythroid precursor cells differentiates to become mature
erythropoietin
primary regulator of the process in maturing RBCs
PRONORMOBLAST
BASOPHILIC NORMOBLAST

POLYCHROMATIC (POLYCHROMATOPHILIC) NORMOBLAST

ORTHOCHROMIC NORMOBLAST

RETICULOCYTE
0.5-1.5%
adult reference range of reticulocyte
2-6%
newborn reference range of reticulocyte
ERYTHROCYTE
MYELOBLASTS
PROMYELOCYTES
NEUTROPHIL MYELOCYTES

NEUTROPHIL METAMYELOCYTES
NEUTROPHIL BANDS
SEGMENTED NEUTROPHILS

EOSINOPHIL MYELOCYTES

EOSINOPHIL

IMMATURE BASOPHILS

MATURE BASOPHILS
MONOBLAST

PROMONOCYTES

MONOCYTE
LYMPHOBLAST

PROLYMPHOCYTE

SMALL LYMPHOCYTES
MEDIUM LYMPHOCYTE
LARGE LYMPHOCYTE
MEGAKARYO BLAST (STAGE 1)
PROMEGARKAYOCYTE (STAGE II)

MEGAKARYOCYTE (STAGE III)

PLATELET (THROMBOCYTE)